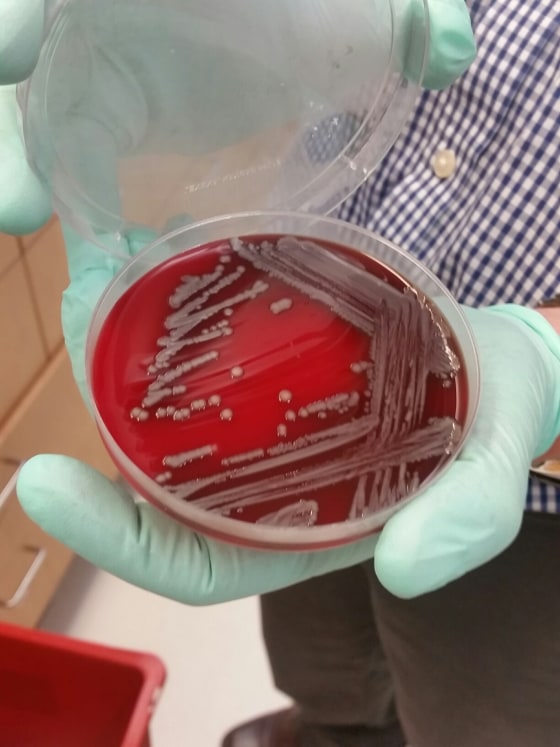
Patrick McGann of the Walter Reed Army Institute of Research displays a culture of multiple drug resistant E coli taken from a Pennsylvania patient.

SILVER SPRING, Md. — It was a Friday in mid-May, and Erik Snesrud was checking out the first batch of samples under a new directive.
The order had just come in to look for a new gene called mcr-1 that had already achieved global notoriety among microbiologists. It gives germs the ability to withstand the effects of colistin, a last-resort antibiotic used to save the lives of people infected with serious superbugs.

The sample was loaded into one of the super-fast gene sequencers at the lab inside the bowels of the Walter Reed Army Institute of Research. The small team at the Multidrug Resistant Organism Repository and Surveillance Network (MRSN) lab specializes in testing germs for antibiotic resistance, which has become the scourge of hospitals all over the world.
The results were back in minutes. One of the samples — some E. coli bacteria taken from a woman with a urinary tract infection in Pennsylvania — carried the gene.
Snesrud knew he was going to lose his weekend. He prepared to work for the next 48 hours. “We wanted to know what we were dealing with,” he said.
The news startled doctors across the country. Center for Disease Control and Prevention director Dr. Thomas Frieden upstaged his own speech about Zika virus last week to warn about what the arrival of mcr-1 means for people everywhere. “The medicine cabinet is empty for some patients. It is the end of the road for antibiotics unless we act urgently,” he said.

Snesrud, however, wasn’t shocked. Once bacteria acquire new characteristics, they generally do get around quickly. The mcr-1 gene had been identified in food animals and people around the world going back for decades. But never before in the United States.
“Everything was going so fast. It was ‘Oh, my God,’” said Patrick McGann, chief of molecular research for the MRSN.
“We got it Friday. We were done Monday afternoon.”
Snesrud’s colleague, Rosslyn Maybank, stayed late that Friday, setting up the giant PacBio sequencing machine that can read out the entire genome of microbes and tell researchers not only what genes can be found in an organism, but where they are.
“We were looking for where the gene was located,” said the quiet and seemingly unflappable Snesrud.

“Was it on the plasmid? Was it in the chromosome?” It was, as expected, on the plasmid — the worst of the two places.
Plasmids are little structures of DNA that exist outside the chromosomes where most of the DNA is found. They’re handy little carriers that can pass off a stretch of DNA as easily as a courier hands an envelope to a client.
Bacteria can acquire resistance to antibiotics in several ways. They can evolve it naturally, through mutations. Or they can share them with one another through what’s known as horizontal gene transfer.
They exchange the plasmid through bacterial sex, often through structures called pili. “They create a little channel and they pass the DNA through it,” McGann said. First, however, they make a copy for themselves, so they can also pass that DNA down to their own daughter cells.
Related: Here's Why Doctors Are Worried About the Superbug
Plasmids come in different types, also, said McGann. He likens them to cars. “Is it a really fast one, like a Ferrari, or is it like a Skoda?” And plasmids don’t respect species distinctions, so bacteria can pass them to different species of bacteria — as if a cat gave some of its genes to a dog, for instance.
It also means doctors don't have to be on the lookout for something as simple as a methicillin resistant staphylococcus aureas (MRSA) infection. They need to watch for an already resistant bacteria that's grabbed some genes from, for example, a type of superbug called carbapenem-resistant enterobacteriaceae or CRE. CRE are the germs that Frieden calls "nightmare bacteria."

In this particular sample, the plasmid was one that can get from one germ to another very quickly. “It was definitely up there with the Lexus or the BMW,” said the chatty, Irish-born McGann.
“We are very concerned to see it in there with this particular plasmid.” Making matters worse, the plasmid was carried by E. coli, itself a highly contagious germ. And this particular E. coli already had superbug characteristics, even before it picked up the new mcr-1 gene.
It has seven of its own resistance genes, permanently encoded in the DNA of its chromosomes. Then it has seven more on the plasmid.
One piece of good news: the E. coli wasn’t invincible — yet. It could be killed with a class of antibiotics called carbapenems. The patient, a 49-year-old woman who hasn’t been identified, was treated with intravenous antibiotics and as now home and well, said Dr. Mary Hinkle, an expert in antibiotic resistance who works on the MRSN team.
“It’s very important to spot these guys coming in early."
CDC and state health officials are helping track down everyone the patient had been in contact with, in hopes of finding where and how she got it.
The big fear is that a CRE will acquire the mcr-1 gene. A patient infected with such a bug would have very little hope of treatment.

Another piece of good news: The MRSN team has not yet found another example of the mcr-1 gene in any of the samples they have tested. “We have tested about another 40 of them so far. There’s no sign of it since,” McGann said.
Related: Superbugs Kill 23,000 People a Year
They are painstakingly going through 40,000 samples of bacteria they have stored in freezers in their labs inside the main blue and yellow building of the Walter Reed annex in Silver Spring, a suburb of Washington, D.C.
Super-fast sequencers developed in the 15 years since the first human genome was mapped help a lot. What used to take weeks or months can now be done in a matter of hours.
A strong work ethic doesn’t hurt, either. Snesrud went two days on little or no sleep; Maybank worked extra hours standing on her feet even though she’s eight months pregnant.
“We pride ourselves on our turnaround time,” McGann said.
There aren’t many rewards — no overtime, no big bonuses for these government employees. But there are some perks. Snesrud’s getting one of the ultimate honors for a microbiologist — a new species named after him. The team has proposed calling it Pseudomonas snesrudii. It was taken from someone’s skin in Baltimore.

The lab tests samples from around the world, not only from U.S. military hospitals but from Israel, France’s Institut Pasteur and elsewhere, McGann said.
Related: Startling New Superbug Found in US for the First Time
“They say, ‘Hey, we have an E.coli here. It’s weird. Can you guys check it out?’” said McGann.
The hope is to catch and stop outbreaks of dangerous new pathogens fast.
“It’s very important to spot these guys coming in early,” says McGann.
One outbreak the team thinks they could have stopped sooner was the spread of a drug-resistant strain of Acinetobacter baumanii that caused an eight-year-long outbreak among servicemembers starting in Iraq in 2002.
A baumanii was known for causing horrible wound infections among soldiers in the Vietnam War. The normally harmless bacteria, found in soil and on skin, got into the wounds of men and women serving in Iraq and Afghanistan, causing baffling bloodstream infections.
“If this lab had existed 15 years ago, we would have been able to provide feedback ... so we could make much smarter choices,” Hinkle said.
“They say, ‘Hey, we have an E.coli here. It’s weird. Can you guys check it out?’”
The team would have been able to sequence the samples quickly and tell military doctors which antibiotic to use, and which patients to isolate so the bug didn’t spread.
Instead, doctors were forced to try one antibiotic after another and had no idea that certain patients were more dangerous than others. Each one failed.
In the end, it was colistin that worked. That’s one reason the team’s so concerned to see mcr-1 and its properties that make colistin useless, too.
The CDC, World Health Organization and other groups warn that it’s only a matter of time before people start becoming infected with ultimate superbugs that cannot be killed by any of the antibiotics in the arsenal.

President Barack Obama has directed government agencies to get busy working on a solution, and the MRSN team at Walter Reed in part of that effort. Other labs in the large blue complex are working to develop antibiotics that will bypass all the known resistance mechanisms, and kill even the worst superbugs.
So are academic centers and a few drug companies, although not as many as experts would like to see. And drug development takes years.
In the meantime, the MRSN team is acting as one of the first lines of defense, trying to catch dangerous superbug infections before they can cause outbreaks.